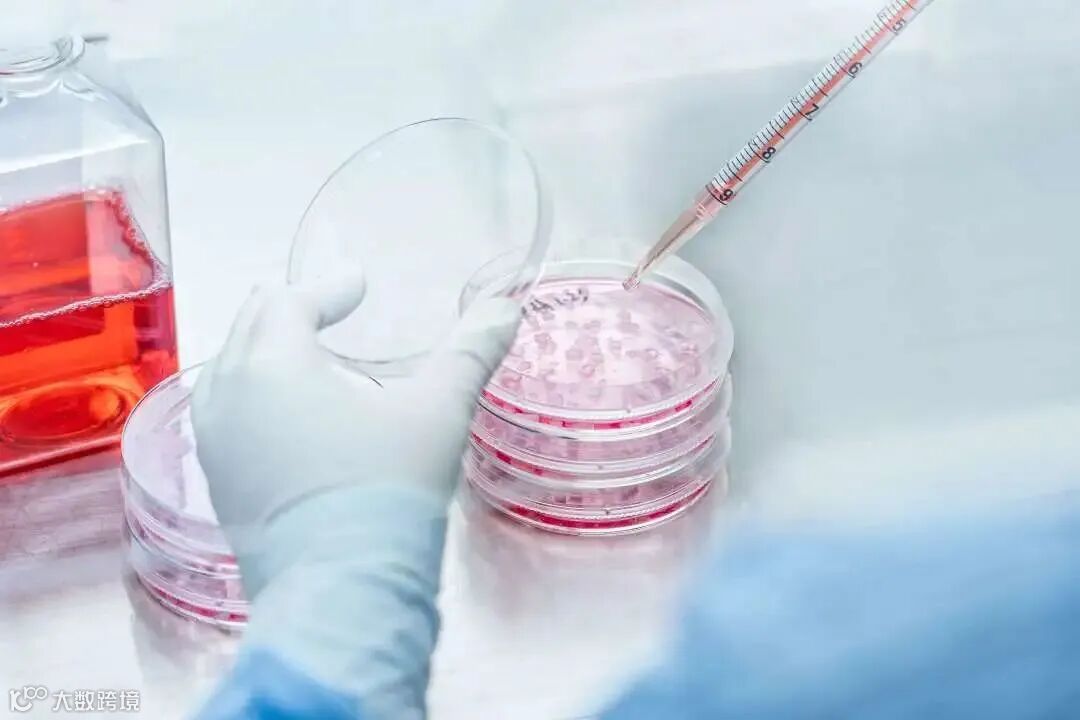

广东省青少年科技教育基地

根据《关于2023年度广东省青少年科技教育基地认定的公示》,经申报、推荐、审核、受理纸质材料、网络评审、现场考察评审等程序,瑞因生命科学科普研学教育基地被认定为“2023年度广东省青少年科技教育基地”。



关于瑞因科普


瑞因科普研学教育基地
精准医学、细胞创新治疗、微生物
瑞因科普研学教育基地位于广州科学城莱迪创新科技园7栋1层,面积2,000平米。科普基地主要分为科普展厅、分子生物学(基因检测)实验室、细胞工程GMP工厂、国家中心细胞库(广州)、基因大数据中心等,作为广东省科普教育基地、广东省青少年科技教育基地、广州市科普资源单位、黄埔区科普活力圈新时代科普实践基地,坚持以传递科普知识为原则,以普及生命科学知识为目标,积极主动开展科普宣传教育工作,发挥大湾区科普基地的优势,加强粤港澳大湾区青少年科普教育、创业就业等方向的交流实践活动。目前已建立根据学龄段建立青少年科普研学、生命科学学科探索(生物医药专业和综合专业)的科普课程体系,并根据素质教育建立生物科技和英语、文旅、美术、阅读、演讲等兴趣爱好结合的特色科普项目,并拓展党建科普游、红培科普游、亲子科普游、科普展馆设计运营等新项目,建立“文、商、旅、教、科”五位一体的科普研学综合体。


精准营养与精准医学
GOODWILLBIO

瑞因生物科普团队依托先进的分子检测技术平台,对人体基因进行检测,基于权威数据库,对基因分型进行分析和解读,致力于为临床提供精准治疗解决方案,为广大青少年提供关于药物基因组学、营养基因组学、基因遗传性疾病、基因检测技术等前沿科技知识,开放分子检测实验室参观通道,通过对实验室内配备的仪器设施的科学普及,包括各类PCR仪器、核酸质谱、测序仪器等分子检测仪技术平台,让广大青少年了解基因检测的原理,基因检测的应用和检测的意义等。






细胞创新治疗
GOODWILLCELL
瑞因细胞工程科技(广州)有限公司(以下简称瑞因细胞™)成立5年,扎根于CGT领域、深耕相关技术的生产和研发,通过不懈的努力,公司通过了国家高新技术企业、专精特新企业、瞪羚企业、绿色企业等认定,并成为广州首家获得细胞行业国际最高AABB认证的企业!
瑞因细胞科普通过开放干细胞GMP工厂参观通道,通过对各实验室内配备的仪器设施的展示讲解,让受众学习诸如从细胞的原代提取、分离培养扩增等一系列过程,探索细胞工程技术的奥秘,理解干细胞与其他细胞的不同功能及作用。科普团队专注于细胞科技的科学普及,致力于传播干细胞、功能细胞、免疫细胞的特点,科普再生医学的科研成果转化及临床应用等科学知识。






微生物鉴定、肠道菌群
Realmeta

瑞因迈拓作为全球首创宏基因组测序分析方法,率先转化感染性疾病辅助诊断临床应用的资深Nature技术团队,团队主要成员先后与南方医科大学陈金军教授团队、南方医科大学南方医院检验科郑磊教授团队合作发表学术文章。科普团队为广大青少年提供最前沿的关于宏基因组高通道测序、微生物鉴定、肠道菌群等方面的科普知识,开放生物信息大数据中心参观通道,采用生物信息大数据服务器的展示,向大众讲解通过综合应用现代分子遗传技术、计算机技术、信息技术等学科知识,并结合分析对象特征,对数据进行序列比对、基因识别、变异检测、蛋白质结构预测、基因表达等分析的生物信息分析技术,以及生物信息分析技术在临床研究与应用上发挥的作用。





瑞因科普将始终坚持
打造专业、负责、优质的
科普志愿服务团队
为每一位青少年提供
生命科学的学习土壤
在青少年心中播下科学的种子
激发青少年的科学好奇心
想象力、探索欲
培育具备科学家潜质
愿意献身科学研究事业的青少年群体